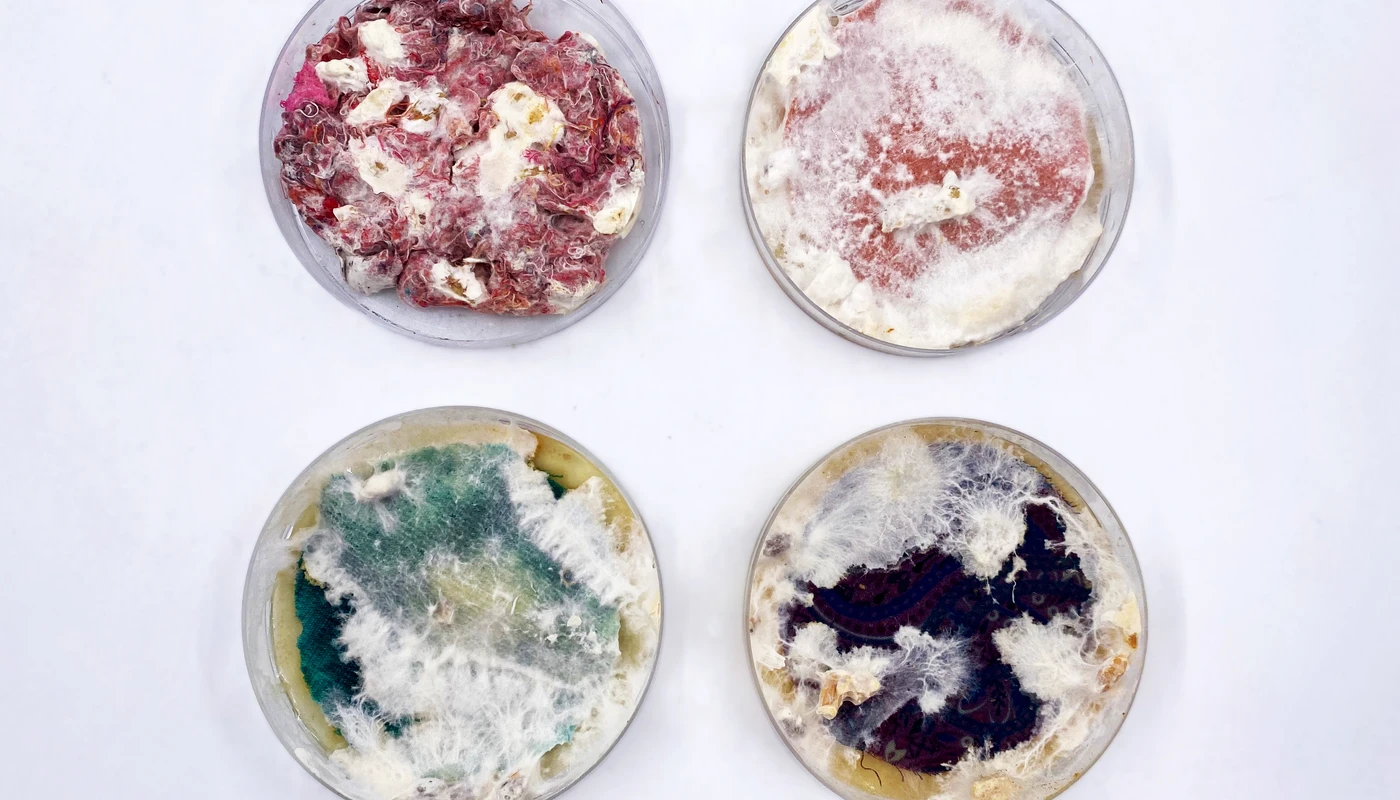
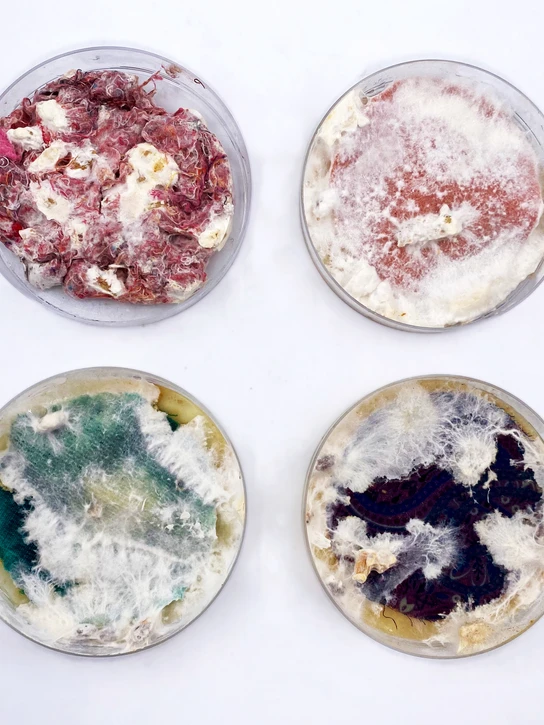

Studenterprojekt
Myceliumsvampe og tekstilaffald
- Designer
-
Ana Schacht
- Uddannelsesniveau
- Kandidat
- Fagområde
- Tekstildesign
- Fokusområde
- Design for Planet
- År
- 2023
Baggrund
Tekstilaffald er en massiv miljømæssig udfordring. Dette projekt løser udfordringen ved at foreslå en cirkulær designtilgang, der bruger myceliumsvampes rodstruktur til, at nedbryde tekstilaffald og omsætte det til brugbart materiale.
Myceliumsvampe og tekstilaffald
Mycelium-baseret teknologi er et nyt felt, der kombinerer biologi og design. Ved at målrette nedbrydningen af cellulosebaserede fibre, såsom bomuld, viskose, modal osv., kan denne proces vise sig som en bæredygtig måde at adskille komplicerede tekstilblandinger, som i øjeblikket er svære at genbruge.


Ana Schact
Kandidatprojekt / 2023 / Design for Planet